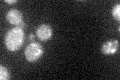
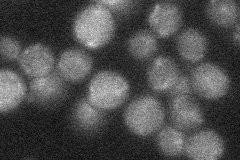

View description
Cu(+2)-transporting P-type ATPase, required for export of copper from the cytosol into an extracytosolic compartment; has similarity to human proteins involved in Menkes and Wilsons diseases
Localization:
Intensity:
Fold change:
Significance:
-
C’ GFP library in SD
punctate22.32 -
N' NOP1pr-GFP in SD

punctate33.099 -
N' TEF2pr-mCherry in SD

vacuole29.125 -
N' NATIVEpr-GFP in SD
below threshold22.572 -
N' TEF2pr-VC and Cyto-VN in SD

below threshold26.2164 -
C’ GFP library in SD+DTT

punctate15.960.71Yes -
C’ GFP library in SD+H2O2

punctate18.050.8Yes -
C’ GFP library in Starvation Media

punctate23.811.06No -
C’ GFP library on the background of Pup2-DaMP

punctate -
C’ GFP library on the background of CCT mutant

punctate16.2280.72698No
